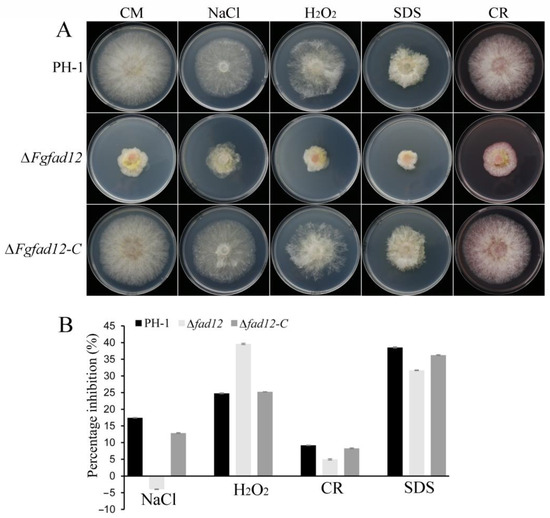
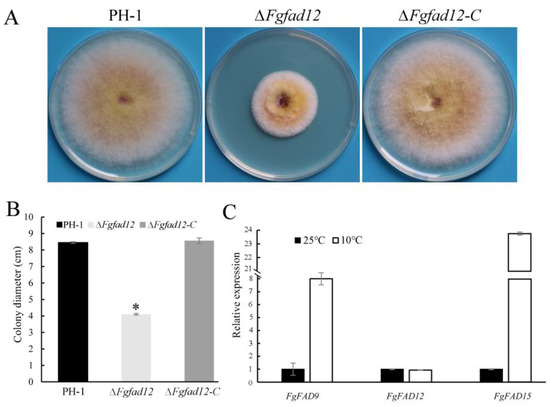

Abstract
Polyunsaturated fatty acids (PUFAs), as important components of lipids, play indispensable roles in the development of all organisms. ∆12 fatty acid desaturase (FAD12) is a speed-determining step in the biosynthesis of PUFAs. Here, we report the characterization of FAD12 in Fusarium graminearum, which is the prevalent agent of Fusarium head blight, a destructive plant disease worldwide. The results demonstrated that deletion of the FgFAD12 gene resulted in defects in vegetative growth, conidial germination and plant pathogenesis but not sexual reproduction. A fatty acid analysis further proved that the deletion of FgFAD12 restrained the reaction of oleic acid to linoleic acid, and a large amount of oleic acid was detected in the cells. Moreover, the ∆Fgfad12 mutant showed increased resistance to osmotic stress and reduced tolerance to oxidative stress. The expression of FgFAD12 did show a temperature-dependent manner, which was not affected at a low temperature of 10 °C when compared to 25 °C. RNA-seq analysis further demonstrated that most genes enriched in fatty acid metabolism, the biosynthesis of unsaturated fatty acids, fatty acid biosynthesis, fatty acid degradation, steroid biosynthesis and fatty acid elongation pathways were significantly up-regulated in the ∆Fgfad12 mutants. Overall, our results indicate that FgFAD12 is essential for linoleic acid biosynthesis and plays an important role in the infection process of F. graminearum.
1. Introduction
Fusarium head blight of wheat, caused by the fungal pathogen Fusarium graminearum, leads to severe devastating food security and economic loss [1,2]. F. graminearum also invades barley and maize, leading to crown rot or stalk rot [3]. In addition to reducing the yield and quality of the grain, F. graminearum also produced several types of mycotoxins, such as type B trichothecenes deoxynivallenol (DON), zearalenone (ZEN) and nivalenol (NIV) during the infection process [4]. DON inhibits protein synthesis in eukaryotic organisms, which is harmful to humans and animals [5,6,7]. Due to its destructive impact on agriculture, F. graminearum is considered one of the top 10 most important fungal plant pathogens worldwide [8]. However, plant diseases are difficult to be controlled in practice because of lacking effective plant resistance cultivars to F. graminearum [9]. Therefore, new approaches to cellular and molecular mechanisms to control F. graminearum have been studied using genomics, transcriptomics and reverse genetics during the last decade [10,11,12,13,14,15,16]. These studies enrich our knowledge of hyphal growth, conidia production and pathogenicity in F. graminearum.
Fatty acids are important components of biofilms, which are responsible for receiving signals from external environmental factors [17]. The changes in the physiological, biochemical and physical properties of the biofilm directly reflect the impact of the environment on organisms. The composition and content of fatty acids are closely related to biological stress resistance [18]. Fatty acids can be divided into saturated fatty acids and unsaturated fatty acids. Two or more double bonds in straight-chain fatty acids containing 18~22 carbon atoms are called polyunsaturated fatty acids (PUFAs). PUFAs mainly contain four groups, including n-3, n-6, n-7 and n-9, that are named based on the position of the first double bond in a carbon chain. The groups of n-3 and n-6 PUFAs play important roles in biological function, such as alpha-linolenic acid (ALA, n-3), eicosapentaenoic acid (EPA, n-3), docosahexaenoic acid (DHA, n-3), linoleic acid (LA, n-6), gamma-linolenic acid (GLA, n-6), and arachidonic acid (ARA, n-6). DHA is a precursor of anti-inflammatory docosanoids and EPA is the substrate for the synthesis of anti-inflammatory eicosanoids. ARA is the precursor of prostaglandins, prostacyclins and leukotrienes involved in inflammatory reactions and immune response [19]. Additionally, PUFAs play a significant role in regulating cell membrane structure, fluidity, signal transduction, material transport, ion exchange, energy transfer and enzyme activity [20,21]. Considering their biological functions, PUFAs are considered key factors in health and disease. PUFAs, especially DHA and EPA, produced from deep-sea fish were popular with humans. However, the reduction of fish resources, the complexity of mining and the increase of marine pollution have become the limiting factors in n-3 PUFA production [22]. Microbial lipids have attracted attention to the production of PUFAs, considering their rich sources. Owing to the easy cultivation, short growth cycle, low production cost and high yield of lipids, oleaginous filamentous fungi have become the main source in PUFA production, and the fungal fermentation of PUFAs has become an international development trend [23,24]. Therefore, analyzing the synthetic pathway and regulation mechanism of PUFAs is conducive to achieving a high quantity of high-quality PUFAs by fungi fermentation technology.
In fungi, under the reaction of different fatty acid desaturases and elongases, the synthesis of PUFAs begins with the dehydrogenation of 18 carbon stearic acid (STA, C18:0) and carbon chain elongation. Various fatty acid desaturases were identified, which can insert the double bond into the carbon chain at a unique position. Delta-5 desaturase (Δ5), Delta-6 desaturase (Δ6), Delta-9 desaturase (Δ9), Delta-12 desaturase (Δ12) and Delta-15 desaturase (Δ15) are well-known fatty acid desaturases. Δ12 desaturase, also known as oleate desaturase, has the capability to introduce a double bond between the 12th and 13th carbon atom counted from the carboxyl group of monounsaturated oleic acid to form polyunsaturated linoleic acid containing two double bonds [25]. Linoleic acid has the physiological effect of reducing the content of cholesterol and triglycerides in blood, preventing Atherosclerosis [26]. Linoleic acid is also the precursor of ALA, GLA, EPA and some physiological regulators such as prostaglandin [26]. The Δ12 desaturase gene of Mortierella alpine was cloned and expressed in Saccharomyces cerevisiae, leading to the production of linoleic acid at levels up to 25% of the total fatty acids [27]. Potatoes contained higher amounts of PUFAs and a higher tolerance to low temperatures and oxidative stress when they were transformed with the Δ12 desaturase gene from Cyanobacterium synechocystis [28]. The Δ12 desaturase gene from Mortierella isabellina was successfully expressed in yeast, tobacco, rapeseed and soybean, which significantly increased the content of fatty acids. In vitro, adding oleic acid and linoleic acid could promote the mycelial growth and asexual spore production of Aspergillus flavus, while adding saturated fatty acid such as palmitic acid had no effect [29]. Similarly, the addition of EPA could promote the production of asexual spores of Aspergillus fumigatus and Aspergillus nidulans [30], indicating that unsaturated fatty acids can regulate the growth and development of fungi.
Δ12 desaturase is the key enzyme for the dehydrogenation of oleic acid to form linoleic acid and a rate-limiting enzyme to synthesize n-3 and n-6 PUFAs metabolic pathways, controlling the production of most PUFAs in organisms. Orthologs of Δ12 desaturase are well conserved, but their roles in plant pathogenic fungi have not been studied during pathogenesis. In this study, we aimed to determine the functions of the FgFAD12 gene in F. graminearum. The ∆Fgfad12 mutant was generated and analyzed for its defects in growth, stress resistance, pathogenesis and LA biosynthesis. In addition, qRT-PCR assay showed that a low temperature stimulated Δ9 and Δ15 fatty acid desaturase gene expression.
2. Materials and Methods
2.1. Fungal Strains and Culture Conditions
The first table in Section 3.2 lists all strains used in this study. All strains were generally cultured on Potato Dextrose Agar (PDA) plates at 25 °C [31]. Colony morphology and growth rate of mutants were measured on Complete Medium (CM) plates at 25 °C for three days. Conidia were obtained in liquid carboxy-methl-cellulose (CMC) medium at 25 °C with shaking at 175 rpm [32]. Conidiation was measured after 5 days by hemocytometer. For stress response assays, strains were cultured on CM plates with 0.7 M NaCl, 0.05% H2O2, 0.01% SDS or 300 μg/mL Congo Red [31]. The characters were recorded 5 dpi.
Sexual reproduction was assayed on carrot agar according to Zheng’s method [33]. Protoplast preparation and polyethylene glycol-mediated fungal transformation were performed as described [32]. Final concentrations of 300 µg/mL hygromycin B (CalBiochem, La Jolla, CA, USA) and 400 µg/mL geneticin (Sigma-Aldrich, St. Louis, MO, USA) were used for transformant selection.
2.2. Generation of Fgfad12 Deletion Mutants
To generate the ∆Fgfad12 mutants, hygromycin phosphotransferase fragments were fused with the upstream and downstream flanking fragments of FgFAD12 gene by overlapping PCR [34]. The upstream and downstream fragments and hygromycin phosphotransferase fragments were amplified with Fad12/1F-2R, Fad12/3F-4R, and HYG/F-R, respectively. The recombination DNA fragments were transformed into the protoplasts of the wild-type PH-1 [35]. The ∆Fgfad12 mutants were screened by PCR with primer pairs Fad12/5F-6R, H850-H852, Fad12/7F-H855R and H856F-Fad12/R. All primers used for PCR are listed in Table S1.
2.3. Generation of the FgFAD12-GFP and Co-Localization Transformants
FgFAD12-GFP fusion construct was generated using the ClonExpress® II One Step Cloning Kit (Vazyme, Nanjing, China). To generate the FAD12-GFP fusion construct, the FAD12 gene with its native promoter was amplified with primer pair Fad12/HF-HR (Table S1). Subsequently, the FAD12 gene fragments were cloned into the pKNT-GFP vector by Hind III/Kpn I double-digested to obtain FAD12-GFP fusion construct [36]. The resulting FgFAD12-GFP fusion construct was transformed into ∆Fgfad12 mutants. Transformants containing hygromycin and genecin resistance were verified by PCR, and GFP signals were observed with epifluorescence microscope (Nikon, DS-Ri1, Tokyo, Japan).
For co-localization transformants, FgKar2-mCherry-T-vector was obtained from Shuli Cao of Jiangsu Academy of Agricultural Sciences. FgKar2-mCherry and Fad12-GFP were co-transformed into the wild-type PH-1. Transformants were examined GFP and mCherry signals with epifluorescence microscope (Nikon, DS-Ri1, Tokyo, Japan).
2.4. Plant Infection Assays and DON Production Assays
For flowering wheat head infection assays, conidia of PH-1 and mutant strains harvested from 5-day-old CMC cultures were resuspended to 2 × 105 spores/mL in sterile distilled water. The flowering wheat heads of cultivar Annong8455 were inoculated with 10 μL of conidia suspension at the fifth spikelet from the base of spike, as previously described [37]. The inoculated wheat heads were examined at 14 days post-inoculation (dpi) to estimate the disease index [38].
For wheat coleoptile infection assays, germ-free scissors were used to remove 1 mm of the tip of the coleoptile, and then cotton drenched with 2 × 105 spores/mL conidia suspension was wrapped around the wound site [39]. Cotton was removed at 2 dpi, and the length of coleoptile stalks infected was measured at 10 dpi. The experiment was conducted three times, and 10 plants were inoculated in each treatment every time.
For corn silks infection assays, fresh corn silks were inoculated with 7 mm blocks of PH-1, and mutant strains were cultured in the dark. The length of corn silks infected was measured at 7 dpi [40].
For DON production assays, 6 g sterile rice was infected with 1 × 105 spores/mL conidia suspension, then fully mixed the rice and conidia. The infected rice was incubated in the dark for 21 days and regularly stirred to prevent clumping. DON production was measured as described [38].
2.5. qRT-PCR Assays
For detecting the expression of ∆9, ∆12 and ∆15 fatty acid desaturase genes, RNA samples were isolated from vegetative hyphae harvested from PDA plates at 10 °C and 25 °C for 6 days with the TRIzol reagent (Invitrogen, Carlsbad, CA, USA). cDNA was synthesized with the M5 Super plus qPCR RT kit with gDNA remover (Beijing, Mei5, China). FgTUB2 was used as internal control [41], and relative expression levels of each gene were calculated by 2−∆∆Ct method [42]. Data from three biological replicates were used to calculate the mean and standard deviation.
2.6. Fatty Acids Analysis
PH-1 and ∆FgFad12 mutant strains conidia were harvested from CMC cultures 5 dpi, resuspended with Yeast Extract Peptone Dextrose Medium (YEPD) and cultured at 25 °C with shaking at 175 rpm. Vegetative hyphae harvested after 24 h were frozen drying in vacuum freeze dryer.
Samples were mixed with 100 μL 5 mg/mL C17 fatty acid methyl ester/petroleum ether solution, 2 mL 5% concentrated sulfuric acid/methanol solution and 300 μL toluene, mixing slightly, and mixture was kept at 95 °C for 1 h in order to trans-esterify lipids. Adding 2 mL 0.9% NaCl and extract with 1 mL n-hexane to mixture was centrifuged at 5000 rpm for 5 min. Fatty acid content of supernatant was detected by gas chromatography (Agilent 7890A, Santa Clara, CA, USA) equipped with flame ionization detector (FID) using DB FastFAME chromatographic column. Fatty acids were identified by comparison of retention times to authentic standards. The relative amounts of fatty acid were determined by peak areas in the total ion chromatograms. Data from three biological replicates were used to calculate the mean and standard deviation.
2.7. RNA-seq Analysis
Vegetative hyphae of PH-1 and ∆FgFad12 mutants were obtained from 18 h YEPD cultures. Total RNA samples were extracted with TRIzol Reagent (Invitrogen, Carlsbad, CA, USA), and mRNA enrichments were used with Oligo (dT) Beads (Thermo Fisher Scientific, Olso, Norway). Strand-specific RNA-seq libraries were prepared with TruseqTM RNA sample prep Kit (San Diego, CA, USA) and sequenced with Illumina Novaseq6000 (San Diego, CA, USA) with a 2 × 150 bp paired-end read mode at the Origingene Bio-pharm Technology firm (Shanghai, China). For each library, at least 20 Mb of paired-end reads were obtained.
The reference genomic sequence of F. graminearum strain PH-1 [43] was used from https://fungi.ensembl.org/Fusarium_graminearum/Info/Index (accessed on 22 June 2023). Reads were mapped onto the reference genome using HISAT2 (version 2.1) [44]. The number of reads aligned to each gene was calculated by RSeQC (version 3.0.1). Differentially expressed genes were analyzed with DESeq2 (version 1.20). Genes with an FDR < 0.05 and log2 fold-change > 1 were considered to be significantly different expressed genes. RNA-seq mappings of all samples were used for assembling transcripts by StringTie [45], and the merged transcript GTF files were applied to the reference gene annotation for CASH. RNA-seq data with GSA number CRA012955 was deposited in National Genomics Data Center.
3. Results
3.1. FgFAD12 Is a Delta-12 Fatty Acid Desaturase in F. graminearum
Delta-12 (∆12) fatty acid desaturase regulates the conversion of oleic acid to linoleic acid. To identify the ∆12 fatty acid desaturase in F. graminearum, PAS_chr4_0052 of Pichia pastoris GS115 as a query sequence was used in a BLAST search in the F. graminearum protein database. FGSG_05784, one putative ∆12 fatty acid desaturase, was identified, named FgFad12. In different species, fatty acid desaturases contain three conserved histone-rich regions. Protein sequence analysis revealed that the amino acid of FgFad12 was conserved in fungi containing HXXXH, HXXHH, and HXXHH sequence features (Figure S1). A bioinformatics analysis showed that FgFad12 contained 475 amino acid residues, and the predicted molecular weight was approximately 53.41 kDa. Four transmembrane helices were distributed in FgFad12 and analyzed by TMHMM-2.0 (Figure 1A).

Figure 1.
The identification of Fad12 ortholog in the genome of F. graminearum. (A) Domain structures of FgFad12. (B) The Neighbor-Joining tree of Fad12 orthologs. The phylogenetic tree was constructed using MEGA 7 with full-length sequences of proteins. FGSG_05784 was marked with red frame. Scale bar corresponds to 0.1 amino acid substitutions per site.
Phylogenetic analysis of amino acid sequences was performed with the Fad12 family in different eukaryotic organisms (Figure 1B). This result showed that FgFad12 orthologs widely exist in filamentous fungi, and FgFad12 has a closer genetic relationship with Fusarium species.
3.2. FgFAD12 Is Required for Vegetative Growth and Conidial Germination, but Not Sexual Reproduction
To explore the function of FgFad12 in F. graminearum, we generated the FgFAD12 deletion mutant via homologous recombination. All mutants had similar phenotypes, although only data for Fgfad12 mutant ∆Fgfad12 was presented below (Table 1). When the wild-type strain PH-1, Fgfad12 mutant ∆FgFad12 and the complementary strain ∆FgFad12-C were cultured on PDA and 5×YEG plates at 25 °C for 3.5 days, the growth rate of Fgfad12 mutant was significantly reduced compared with PH-1 and ∆FgFad12-C (Figure 2A,B; Table 2). The asexual reproduction of the ∆Fgfad12 was detected in a CMC medium cultured for 5 days. In comparison with PH-1 and the complementary strain, the conidiation of the Fgfad12 mutant was not reduced (Table 2), suggesting that the deletion of FgFAD12 does not affect conidiation in F. graminearum. However, the conidial germination of the ∆Fgfad12 was significantly reduced, observed at 4 h and 8 h hyphae cultured in YEPD medium (Figure 2C).

Table 1.
Wild type and transformants of Fusarium graminearum strains used in this study.

Figure 2.
Phenotypes of ∆Fgfad12 mutant in vegetative growth, conidial germination and sexual reproduction. (A) The wild-type PH-1, ∆Fgfad12 mutant and ∆Fgfad12-C strains were cultured on PDA and 5 × YEG plates for 3.5 days. (B) Colony diameters of PH-1, ∆Fgfad12 and ∆Fgfad12-C strains. Mean and standard deviation were calculated with data from three replicates. Asterisk indicates a statistically significant difference (p < 0.05) by Duncan’s multiple range test. (C) Conidial germination of PH-1, ∆Fgfad12 mutant and ∆Fgfad12-C strains. Conidia were incubated in YEPD liquid medium, and images were taken at 0 h, 4 h and 8 h post-incubation. Bar = 20 μm. (D) Perithecia and ascospores on carrot agar cultures of PH-1, ∆Fgfad12 mutant and ∆Fgfad12-C strains were examined after 10 days post-fertilization. Bar = 20 μm.

Table 2.
Defects of strains in growth, conidiation, pathogenicity and DON production.
Sexual reproduction plays a critical role in the infection cycle of F. graminearum. To analyze the effect of the FgFAD12 gene on the sexual reproduction of F. graminearum, we cultured the Fgfad12 mutant on carrot plates at 10 days post-fertilization or even longer to observe the perithecium and ascospores formation. The ∆FgFad12 mutant produced a similar number of perithecia and normal ascopores in comparison with PH-1 (Figure 2D). These results indicate that FgFAD12 plays an important role in vegetative growth conidia germination but is dispensable when it comes to sexual reproduction.
3.3. FgFAD12 Is Involved in Various Stress Responses
To examine the stress response of ∆Fgfad12 mutant, all strains were cultured on CM plates with 0.7 mol/L NaCl, 0.05% H2O2, 300 μg/mL Congo red and 0.01% SDS, respectively. The results showed that the inhibition rate of ∆Fgfad12 mutant was lower than PH-1 and ∆Fgfad12-C strains on CM medium with NaCl, Congo red and SDS (Figure 3A,B), indicating that cell membrane and cell wall integrity are increased in ∆Fgfad12 mutant. Compared with PH-1 and ∆Fgfad12-C, the percentage inhibition of ∆Fgfad12 mutant was increased on CM medium with H2O2 (Figure 3A,B), indicating that ∆Fgfad12 mutant decreases the tolerance to oxidative stress. Taken together, these results indicate that FgFAD12 is involved in response to hyperosmotic conditions, cell destabilization and oxidative stress.
Figure 3.
Phenotypes of ∆Fgfad12 mutant in stress sensitivity. (A) PH-1, ∆Fgfad12 and ∆Fgfad12-C strains were cultured on CM plates with or without 0.7 mol/L NaCl, 0.05% H2O2, 300 μg/mL Congo red and 0.01% SDS for 3 days. (B) Mycelial growth percentage inhibition of PH-1, ∆Fgfad12 and ∆Fgfad12-C strains. Mean and deviation were calculated with data from three biological replicates.
3.4. FgFAD12 Is Essential for Pathogen Virulence
To investigate the role of FgFAD12 in plant infection, flowering wheat heads were point inoculated with conidial suspensions of PH-1, ∆FgFad12 and ∆FgFad12-C strains. At 14 days post-inoculation (dpi), the average disease index of the Fgfad12 mutant was 3.2 (Table 2). Compared with PH-1 15.2 and ∆FgFad12-C 14.6, the virulence of Fgfad12 mutant was significantly reduced (Figure 4A,D, Table 2). To confirm this result, culture blocks of the same strains inoculated wheat coleoptiles and corn silks. Consistent with the mycelial growth results, the Fgfad12 mutant also showed attenuated virulence as compared with PH-1 and ∆Fad12-C (Figure 4B,C,E,F, Table 2). These results implied that FgFAD12 plays an essential role in plant infection of F. graminearum.

Figure 4.
Defects in pathogenicity of ∆Fgfad12 mutant. (A) Flowering wheat heads inoculated with PH-1, ∆Fgfad12 and ∆Fgfad12-C strains were photographed 14 days post-inoculation (dpi). Black dots mark the inoculated spikelet. (B) Wheat coleoptiles were inoculated with the same strains and photographed at 14 dpi. (C) Corn silks were inoculated with culture blocks of the same set of strains, and photographs were taken at 6 dpi. (D) Disease index of the three strains determined at 14 dpi. More than 15 wheat heads were examined in each replicate. (E) Lesion length was examined in at least three biological replicates of each strain. (F) Lesion length was estimated with data from 20 coleoptiles of each strain. Asterisks indicate a statistically significant difference (p < 0.05) by Duncan’s multiple range test.
DON is an important virulence factor for F. graminearum infection. We also assayed DON production in the infected rice grain cultures. In comparison with the wild type, the ∆FgFad12 mutant was significantly reduced in DON production (Table 2), suggesting that deletion of FgFAD12 affects DON biosynthesis in F. graminearum.
3.5. Subcellular Localization of FgFad12 to the ER
For complementation assays, the FgFAD12-GFP fusion construct was generated and transformed into the ∆FgFad12 mutant strain. The resulting complemented transformant ∆Fad12-C had the wild-type phenotype (Figure 2A), indicating that the functions of FgFad12 were not affected by fusion with GFP protein and the deletion of FgFAD12 is directly responsible for the defects observed in the ∆FgFad12 mutant. When examined by epifluorescence microscopy, GFP signals were observed only in the endoplasmic reticulum (ER) (Figure 5). ER localization of FgFad12 was consistent with Euk-mPLoc 2.0 (http://www.Csbi-o.sjtu.edu.cn/cgi-bin/EukmPLoc2.cgi, accessed on 12 September 2023) [47]. To confirm this observation, we co-transformed the FgFAD12-GFP and FgKAR2-mCherry into the wild-type strain PH-1. In the resulting transformant CL3, both GFP and mCherry signals were observed in the ER of hyphae (Figure 5). These results indicated that FgFad12 localizes to the ER.

Figure 5.
Subcellular localization of the FgFad12-GFP fusion protein. At 12 h, germlings of transformant expressing FgFAD12-GFP and FgKAR2-mCherry were examined by DIC and epifluorescence microscopy. Bar = 20 μm.
3.6. Low Temperature Affects the Expression of Fatty Acid Desaturases
To assay the growth rate of the ∆Fgfad12 mutant at low temperature, PH-1, ∆FgFad12 and ∆FgFad12-C were cultured on PDA plates at 10 °C for 10 days. Compared with the wild type PH-1, reduced by 50.6% at 25 °C, the ∆FgFad12 mutant was reduced by approximately 51.5% in growth rate when cultured in 10 °C condition (Figure 6A,B). These results indicate that the FgFAD12 gene is dispensable for low temperatures in F. graminearum.
Figure 6.
Assays for ∆Fgfad12 mutant phenotype and desaturase genes expression at 10 °C. (A) The wild-type PH-1, ∆Fgfad12 mutant and ∆Fgfad12-C strains were cultured on PDA plates for 10 days at 10 °C. (B) Colony diameters of PH-1, ∆Fgfad12 and ∆Fgfad12-C strains. Colony diameters were estimated with three biological replicates of each strain. Asterisk indicates a statistically significant difference (p < 0.05) by Duncan’s multiple range test. (C) The expression levels of FAD9, FAD12 and FAD15 were assayed by qRT-PCR with PH-1 RNA isolated from 6-day vegetative hyphae cultured on PDA plates at 25 °C and 10 °C. The expression level of each gene in PH-1 was arbitrarily set to 1. Mean and deviation were calculated with data from three biological replicates.
PUFA content is a crucial factor in enhancing membrane fluidity for organism adaptation to low temperatures [48,49]. FAD9, FAD12 and FAD15 fatty acid desaturases are important enzymes in the biosynthesis of PUFAs [50]. To determine the expression level of these genes in low-temperature conditions, RNA samples were isolated from 6 days of vegetative hyphae of the wild-type PH-1 cultured on 10 °C and 25 °C PDA plates. Compared with 25 °C, the expression levels of FgFAD9 and FgFAD15 were up-regulated over 8- and 23-fold, respectively, in 10 °C growth conditions (Figure 6C). However, the expression level of FAD12 was not changed (Figure 6C). These results reveal that low temperature induces the expression of fatty acid desaturase genes to increase PUFA content.
3.7. ∆Fgfad12 Mutant Is Defective in LA Formation
To determine whether the deletion of the FgFAD12 gene affected fatty acid content, 24 h hyphae of the wild-type PH-1 and ∆Fgfad12 mutant cultured at 25 °C were harvested for detection. Fatty acids with chain lengths of 10, 16 and 18 carbons in their saturated and unsaturated forms were detected, the C18 ones accounting for about 87% and 93% in PH-1 and ∆Fgfad12 mutants, respectively. Fatty acids content of C10:0, C16:0 and C18:0 was similar between PH-1 and ∆Fgfad12 mutant strains. In the ∆Fgfad12 strain, the deletion of FgFAD12 led to a lack of linoleic acid (C18:2), while oleic acid (C18:1) was highly accumulated (Table 3). Linolenic acid of ∆Fgfad12 mutant accounted for 1.96% was declined severely in comparison with 25.82% of the wild type PH-1. The desaturation pathway was almost blocked because of the FgFAD12 deletion. These results showed that the catalysis from oleic acid to linoleic acid is mainly responsible for FgFAD12 in F. graminearum.

Table 3.
Fatty acids content of PH-1 and ∆FgFad12 strains.
3.8. FgFad12 Affects Unsaturated Fatty Acid Biosynthesis
To explore the effects on gene transcription, we performed RNA-seq analysis with RNA isolated from 18 h hyphae of PH-1 and ∆Fgfad12 mutant collected from YEPD cultures. Compared with PH-1, 1611 differentially expressed genes (721 up-regulated and 890 down-regulated) were detected in the ∆Fgfad12 mutant (Figure 7A), accounting for 17.1% of total expressed genes. Gene Ontology (Go) terms enrichment analysis was performed on differentially expressed genes. Most down-regulated genes play roles in cytoplasmic translation, organonitrogen compound metabolic process, cellular biosynthetic process, ribosomal subunit biogenesis and ribosome assembly (Figure 7B). However, up-regulated genes were enriched in different Go terms. In the biological process category, genes were enriched in the cellular lipid metabolic process, fatty acid metabolic process, fatty acid biosynthetic process, lipid biosynthetic process and sterol biosynthetic process (Figure 7C). In the molecular function category, fatty acid synthase activity, fatty-acyl-CoA synthase activity and acetate-CoA ligase activity were changed significantly in the ∆Fgfad12 mutant (Figure 7C).

Figure 7.
RNA-seq analysis of Fgfad12 mutant. (A) Volcano plot of significantly different genes in the Fgfad12 mutant. The numbers of up-regulated and down-regulated genes (log2FC > 1, p value < 0.05) with standard deviation were calculated with data from three biological replicates. (B) Gene Ontology (GO) terms enrichment analysis for significantly down-regulated genes. (C) Gene Ontology (GO) terms enrichment analysis for significantly up-regulated genes. BP, biological process; CC, cell component; MF, molecular function. (D) Top KEGG pathway terms for significantly down-regulated genes. (E) Top KEGG pathway terms for significantly up-regulated genes.
KEGG pathway analysis was performed to reveal gene function in the signaling pathway. Among the down-regulated genes, 78 genes were involved in 60 and 40 subunits biosynthesis of ribosome (Figure 7D). Other down-regulated genes were related to starch and sucrose metabolism, amino sugar and nucleotide sugar metabolism, galactose metabolism and carotenoid biosynthesis (Figure 7D). In the up-regulated genes group, fatty acid metabolism was the top pathway, followed by biosynthesis of unsaturated fatty acids, citrate cycle, fatty acid degradation and steroid biosynthesis (Figure 7E). Sterols are essential membrane components and regulate membrane permeability, fluidity, stability, aerobic metabolism and the activities of membrane-bound enzymes [51,52]. Ergosterol is a fungal-specific sterol and is the major sterol of the plasma membrane [53]. A total of 8 genes involved in ergosterol biosynthesis were increased significantly in the ∆Fgfad12 mutant. To analyze the ergosterol content of PH-1 and ∆Fgfad12 strains, 5 days of aerial hyphae of the wild-type PH-1 and ∆Fgfad12 mutant cultured on PDA plates were harvested. The ergosterol content of 87.42 × 10−4% of the ∆Fgfad12 mutant was higher than the PH-1 ergosterol content of 60.98 × 10−4% (Table S3). This result indicated that the deletion of the FgFAD12 gene stimulates the biosynthesis of ergosterol, which supports the RNA-seq data. RNA-seq analysis and ergosterol content assay demonstrated that the ∆Fgfad12 mutant improves the production of ergosterol by increasing the expression levels of the key enzymes of the sterol synthesis pathway, thereby enhancing the integrity of the plasma membrane.
4. Discussion
As a receptor for organisms, cell membranes can directly respond to physiological and biochemical changes and quickly adapt to adverse conditions. The biological activity of cell membranes relies on the lipid bilayer composed of membrane lipids and membrane proteins and the biofilm fluidity [54]. Fatty acids, especially PUFAs, are the major structural components of cell membranes. Through changing the membrane composition, fatty acids provide various biological effects to regulate transcription and cellular signaling [55]. Δ12 fatty acid desaturase plays a key role in PUFA biosynthesis. In this study, we first presented the functional characterization of ∆12 fatty acid desaturase (FgFad12) in F. graminearum.
The deletion of FgFAD12 resulted in a significantly reduced growth rate and conidia germination but is dispensable for conidiation and sexual reproduction. Fad12 orthologs are conserved in ascomycetes, but the functions of this gene in oleaginous yeast and pathogenic filamentous fungi were not exactly the same. In Yarrowia lipolytica, the growth of the ∆fad2 strain was comparable to the wild-type strain at 30 °C on the YNB medium containing various carbon sources [56]. In Aspergillus parasiticus, the growth of the Δ12-desaturase mutant was decreased twofold. Moreover, spore germination, conidiation and sclerotial development were also inhibited compared to wild-type strains [57]. In Aspergillus nidulans, the ∆odeA (∆12 desaturase) deletion mutant was reduced in conidial production and vegetative growth, even though the ratio of asexual spores to ascospores is affected [58]. The exogenous addition of linoleic acid can promote mycelial growth and asexual spore production in Aspergillus flavus. These results indicate that ∆12 fatty acid desaturase genes with conserved sequences and structures showed varied biological functions in different fungi.
In the stress sensitivity, compared with PH-1, the ∆Fgfad12 mutant was more sensitive to H2O2. This result is consistent with Peyou-Ndi’s research. The transformed Saccharomyces cereviase strain showed higher resistance to ethanol and oxidative when the heterologously expressed ∆12 fatty acid desaturase gene was isolated from Caenorhabditis elegans [59]. Interestingly, the ∆Fgfad12 mutant was more tolerant to SDS and CR, indicating that the deletion of FgFAD12 enhances the cell membrane and cell wall integrity. The deletion of FgFAD12 blocked PUFA biosynthesis, thereby decreasing the cell membrane fluidity and enhancing the rigidity of the cell membrane. The increased ergosterol content of the ∆Fgfad12 mutant also enhanced the rigidity of the cell membrane. The increased tolerance to SDS may relate to the changes in the rigidity of the cell membrane. Ergosterol is also involved in the maintenance of cell wall integrity. The increased ergosterol leads to the remodeling of the cell wall, making it more difficult for chitin and β-1,3-glucans on the cell wall to be exposed, ultimately making the ∆Fgfad12 mutant insensitive to CR [60]. Compared with the 17% growth inhibition of PH-1, the ∆Fgfad12 mutant had 4% growth promotion when cultured with 0.7 mol/L NaCl, suggesting that the deletion of the FgFAD12 gene makes mutants more adaptable to a high-permeability environment. The composition and content of fatty acids affect the functions of cell membranes and walls. In Pichia pastoris, the deletion of FAD9A caused a decrease in plasma membrane unsaturation levels and an increase in the tolerance to SDS and hyperosmotic stress [61]. When Rhizopus R31.6 is cultured on a 2% salt medium, in unsaturated fatty acid (UFA), including oleic acid, the content of linoleic acid and linoleic acid are all significantly reduced [62]. The physical properties of plasma membranes, such as fluidity and rigidity, are determined by the lipid composition of biofilms [63]. In other words, increased UFA levels raise the membrane fluidity, and conversely, decreased UFA levels lead to enhanced rigidity. In addition, RNA-seq analysis displayed that the expression levels of eight genes (FGSG_06215, FGSG_04994, FGSG_02502, FGSG_02783, FGSG_05740, FGSG_01000, FGSG_04092 and FGSG_09830) related to ergosterol biosynthesis were prominently increased in the mutant strains compared with wild type. Ergosterol extraction assay revealed that the ergosterol content in the ∆Fgfad12 mutant is 1.4 times higher than the wild-type PH-1 (Table S3). Ergosterol is abundant in fungal plasma membranes and plays an important role in plasma membrane integrity, fluidity and permeability [64,65]. The membrane integrity of the plasma membrane may be rescued by increased production of ergosterol in the ∆Fgfad12 mutant.
Wheat head, wheat coleoptile and corn silk infection assays showed that the FgFAD12 gene plays a critical role in plant infection. The ∆Fgfad12 mutant reduced growth rate and had increased sensitivity to H2O2 (Figure 2B and Figure 3B), which may contribute to its defects in plant infection. Fatty acid analysis showed that the deletion of the FgFAD12 gene barely produced PUFAs in F. graminearum (Table 3). PUFAs are essential for the growth and virulence of pathogens [66,67,68]. In addition, according to RNA-seq data, decreased expression levels of genes in the ∆Fgfad12 mutant, including FGSG_02279, FGSG_04745 and FGSG_05042, played roles in plant infection [49,69,70]. The reduced expression of these genes may also contribute to defects of ∆Fgfad12 mutant in plant infection.
In the present study, we found that the expression levels of ∆9 and ∆15 desaturases were substantially increased, but ∆12 desaturases had no obvious change when F. graminearum was cultivated at 10 °C compared with that at 25 °C. ∆9 is the only desaturase existing in all types of organisms, which play an indispensable role in maintaining the appropriate fluidity of biofilms during evolution [17]. Compared with other fatty acid desaturases, the activity of ∆9 desaturases was mostly involved in changing the membrane fluidity during temperature variation [71,72]. In fungi, low temperature improving the expression level of ∆15 desaturase causing omega-3 fatty acid production was proverbial [73,74]. However, according to Kosa’s study, the ∆15 desaturase activity showed opposite results in different species from a genus. Low temperatures (15 °C and 20 °C) enhance the activity of ∆15 desaturase, leading to an increase in ALA production in Mucor flavus CCM 8086 and VKM F-1003 [75]. Nevertheless, this study also found that the production of ALA was reduced due to the much weaker activity of ∆15 desaturase in Mucor flavus VKM-1097 cultured at 20 °C low temperature [75]. The ∆15 desaturase activity presents contrary regulation at low-temperature cultivation in different strains. In Rhodotorula glutinis YM25079, the expression level of ∆12 desaturase elevated five-fold when strain grown temperature from 25 °C to 15 °C [76]. Under low temperatures, the expression levels of all desaturase genes except ∆5 were increased in Mortierella sp. AGED [77]. In our study, the expression levels of ∆9 and ∆15 desaturases were up-regulated over 8- and 23-fold, respectively, in 10 °C growth conditions; the activity of ∆12 desaturase had no change.
According to the content of fatty acids, the deletion of FgFAD12 led to the reduction of linoleic acid, 1.96% linolenic acid was detected. Based on unsaturated fatty acid biosynthesis of F. graminearum in KEGG, FGSG_05784 (FgFAD12) and FGSG_07890 (FgFAD15) both catalyze OA to LA in n-3 PUFAs biosynthesis pathway. FgFAD15 plays the part of catalyzing OA to LA and then to ALA. It is possible that FgFAD12 and FgFAD15 have overlapping functions in catalyzing OA to LA in n-3 PUFA biosynthesis. It will be important to characterize the functional relationship of FgFad12 and FgFad15 and other desaturases in F. graminearum.
5. Conclusions
This study characterized FgFAD12 in F. graminearum and revealed that FgFAD12 was important in the biosynthesis of LA, vegetative growth and plant infections but had no effect on asexual and sexual reproduction. The deletion of FgFAD12 led to an increased resistance to osmotic stress and reduced tolerance to oxidative stress. Different from FgFAD9 and FgFAD15, the expression of FgFAD12 was not affected by temperatures. These results contribute to revealing the mechanism of unsaturated fatty acids regulating F. graminearum pathogenesis and provide a basis for the synthesis of unsaturated fatty acids in other oil-producing filamentous fungi.
Supplementary Materials
The following supporting information can be downloaded at: https://www.mdpi.com/article/10.3390/jof10040288/s1, Figure S1: Multiple alignments of FgFAD12 with its orthologs from different fungi; Table S1: The primers used in this study; Table S2: Expression level of 1611 DEGs identified between the ∆Fgfad12 mutant and the wild type PH-1; Table S3: Ergosterol content of PH-1 and ∆Fgfad12 strains.
Author Contributions
Conceptualization, Y.Z., Z.G. and A.G.; methodology, Y.Z., Z.G. and L.S.; investigation, Y.Z., W.H., J.L., M.S., Y.D. and G.Y.; data curation, Y.Z.; writing—original draft preparation, Y.Z.; writing—review and editing, Y.Z., Y.D. and A.G.; supervision, Y.L.; funding acquisition, Z.G., Y.Z. and A.G. All authors have read and agreed to the published version of the manuscript.
Funding
This research was funded by the National Natural Science Foundation of China (No. 22208276), Project of Science and Technology Plan of Henan Province (No. 232102110202), Science and Technology Development Plan of Henan Province (No. 212102110477), Natural Science Foundation of Henan Province (No. 222300420519, 222301420111) and Key Research Projects of Higher Education Institutions of Henan Provincial Department of Education (No. 24A210025).
Institutional Review Board Statement
Not applicable.
Informed Consent Statement
Not applicable.
Data Availability Statement
RNA-seq data were deposited in the Genome Sequence Archive in the National Genomics Data Center, China National Center for Bioinformation/Beijing Institute of Genomics, Chinese Academy of Sciences (GSA: CRA012955) that are publicly accessible at https://ngdc.cncb.ac.cn/gsa (accessed on 8 October 2023).
Acknowledgments
We thank Jin-rong Xu at NWAFU-Purdue Joint Research Center for the generous gift of strains and vectors used in this study.
Conflicts of Interest
The authors declare no conflicts of interest.
References
- Bai, G.; Shaner, G. Management and resistance in wheat and barley to fusarium head blight. Annu. Rev. Phytopathol. 2004, 42, 135–161. [Google Scholar] [CrossRef] [PubMed]
- Goswami, R.S.; Kistler, H.C. Heading for disaster: Fusarium graminearum on cereal crops. Mol. Plant Pathol. 2004, 5, 515–525. [Google Scholar] [CrossRef] [PubMed]
- Santiago, R.; Reid, L.M.; Arnason, J.T.; Zhu, X.; Martinez, N.; Malvar, R.A. Phenolics in maize genotypes differing in susceptibility to Gibberella stalk rot (Fusarium graminearum Schwabe). J. Agric. Food Chem. 2007, 55, 5186–5193. [Google Scholar] [CrossRef] [PubMed]
- Chen, Y.; Kistler, H.C.; Ma, Z. Fusarium graminearum Trichothecene Mycotoxins: Biosynthesis, Regulation, and Management. Annu. Rev. Phytopathol. 2019, 57, 15–39. [Google Scholar] [CrossRef] [PubMed]
- De Walle, J.V.; Sergent, T.; Piront, N.; Toussaint, O.; Schneider, Y.J.; Larondelle, Y. Deoxynivalenol affects in vitro intestinal epithelial cell barrier integrity through inhibition of protein synthesis. Toxicol. Appl. Pharmacol. 2010, 245, 291–298. [Google Scholar] [CrossRef] [PubMed]
- Desjardins, A.E.; Proctor, R.H. Molecular biology of Fusarium mycotoxins. Int. J. Food Microbiol. 2007, 119, 47–50. [Google Scholar] [CrossRef] [PubMed]
- Pestka, J.J. Deoxynivalenol: Mechanisms of action, human exposure, and toxicological relevance. Arch. Toxicol. 2010, 84, 663–679. [Google Scholar] [CrossRef] [PubMed]
- Dean, R.; Van Kan, J.A.; Pretorius, Z.A.; Hammond-Kosack, K.E.; Di Pietro, A.; Spanu, P.D.; Foster, G.D. The Top 10 fungal pathogens in molecular plant pathology. Mol. Plant Pathol. 2012, 13, 414–430. [Google Scholar] [CrossRef]
- Buerstmayr, H.; Ban, T.; Anderson, J.A. QTL mapping and marker-assisted selection for Fusarium head blight resistance in wheat. Plant Breed. 2009, 128, 1–26. [Google Scholar] [CrossRef]
- Kazan, K.; Gardiner, D.M. Transcriptomics of cereal-Fusarium graminearum interactions: What we have learned so far. Mol. Plant Pathol. 2018, 19, 764–778. [Google Scholar] [CrossRef]
- Liu, H.; Wang, Q.; He, Y.; Chen, L.; Hao, C.; Jiang, C.; Xu, J.R. Genome-wide A-to-I RNA editing in fungi independent of ADAR enzymes. Genome Res. 2016, 26, 499–509. [Google Scholar] [CrossRef] [PubMed]
- Liu, H.; Zhang, S.; Ma, J.; Dai, Y.; Li, C.; Lyu, X.; Xu, J.R. Two Cdc2 Kinase Genes with Distinct Functions in Vegetative and Infectious Hyphae in Fusarium graminearum. PLoS Pathog. 2015, 11, e1004913. [Google Scholar] [CrossRef][Green Version]
- Sridhar, P.S.; Trofimova, D.; Subramaniam, R.; González-Peña Fundora, D.; Foroud, N.A.; Allingham, J.S.; Loewen, M.C. Ste2 receptor-mediated chemotropism of Fusarium graminearum contributes to its pathogenicity against wheat. Sci. Rep. 2020, 10, 10770. [Google Scholar] [CrossRef]
- Wang, C.; Wang, Y.; Zhang, L.; Yin, Z.; Liang, Y.; Chen, L.; Zou, S. The Golgin Protein RUD3 Regulates Fusarium graminearum Growth and Virulence. Appl. Environ. Microbiol. 2021, 87, e02522-20. [Google Scholar] [CrossRef]
- Yang, B.; Wang, Y.; Tian, M.; Dai, K.; Zheng, W.; Liu, Z.; Wang, Y. Fg12 ribonuclease secretion contributes to Fusarium graminearum virulence and induces plant cell death. J. Integr. Plant Biol. 2021, 63, 365–377. [Google Scholar] [CrossRef] [PubMed]
- Zhang, Y.; Gao, X.; Sun, M.; Liu, H.; Xu, J.R. The FgSRP1 SR-protein gene is important for plant infection and pre-mRNA processing in Fusarium graminearum. Environ. Microbiol. 2017, 19, 4065–4079. [Google Scholar] [CrossRef]
- Klempova, T.; Mihalik, D.; Certik, M. Characterization of membrane-bound fatty acid desaturases. Gen. Physiol. Biophys. 2013, 32, 445–458. [Google Scholar] [CrossRef] [PubMed]
- Mishra, N.N.; Ali, S.; Shukla, P.K. Arachidonic acid affects biofilm formation and PGE2 level in Candida albicans and non-albicans species in presence of subinhibitory concentration of fluconazole and terbinafine. Braz. J. Infect. Dis. 2014, 18, 287–293. [Google Scholar] [CrossRef]
- Dong, W.; Chen, Y.; Zhang, Q.; Zhao, X.; Liu, P.; He, H.; Zhang, Y. Effects of lipoteichoic and arachidonic acids on the immune-regulatory mechanism of bovine mammary epithelial cells using multi-omics analysis. Front. Vet. Sci. 2022, 9, 984607. [Google Scholar] [CrossRef]
- Burdge, G.C. Is essential fatty acid interconversion an important source of PUFA in humans? Br. J. Nutr. 2019, 121, 615–624. [Google Scholar] [CrossRef]
- Dyall, S.C.; Balas, L.; Bazan, N.G.; Brenna, J.T.; Chiang, N.; da Costa Souza, F.; Taha, A.Y. Polyunsaturated fatty acids and fatty acid-derived lipid mediators: Recent advances in the understanding of their biosynthesis, structures, and functions. Prog Lipid Res. 2022, 86, 101165. [Google Scholar] [CrossRef] [PubMed]
- McKenzie, D.J.; Axelsson, M.; Chabot, D.; Claireaux, G.; Cooke, S.J.; Corner, R.A.; Metcalfe, J.D. Conservation physiology of marine fishes: State of the art and prospects for policy. Conserv. Physiol. 2016, 4, cow046. [Google Scholar] [CrossRef] [PubMed]
- Klempová, T.; Slaný, O.; Šišmiš, M.; Marcinčák, S.; Čertík, M. Dual production of polyunsaturated fatty acids and beta-carotene with Mucor wosnessenskii by the process of solid-state fermentation using agro-industrial waste. J. Biotechnol. 2020, 311, 1–11. [Google Scholar] [CrossRef] [PubMed]
- Nazir, Y.; Shuib, S.; Kalil, M.S.; Song, Y.; Hamid, A.A. Optimization of culture conditions for enhanced growth, lipid and docosahexaenoic acid (DHA) production of aurantiochytrium SW1 by response surface methodology. Sci. Rep. 2018, 8, 8909. [Google Scholar] [CrossRef] [PubMed]
- Takeno, S.; Sakuradani, E.; Tomi, A.; Inohara-Ochiai, M.; Kawashima, H.; Ashikari, T.; Shimizu, S. Improvement of the fatty acid composition of an oil-producing filamentous fungus, Mortierella alpina 1S-4, through RNA interference with delta12-desaturase gene expression. Appl. Environ. Microbiol. 2005, 71, 5124–5128. [Google Scholar] [CrossRef] [PubMed][Green Version]
- Dobryniewski, J.; Szajda, S.D.; Waszkiewicz, N.; Zwierz, K. Biology of essential fatty acids (EFA). Przegl. Lek. 2007, 64, 91–99. [Google Scholar]
- Huang, Y.S.; Chaudhary, S.; Thurmond, J.M.; Bobik, E.G., Jr.; Yuan, L.; Chan, G.M.; Knutzon, D.S. Cloning of delta12- and delta6-desaturases from Mortierella alpina and recombinant production of gamma-linolenic acid in Saccharomyces cerevisiae. Lipids 1999, 34, 649–659. [Google Scholar] [CrossRef]
- Maali-Amiri, R.; Goldenkova-Pavlova, I.V.; Yur’eva, N.O.; Pchelkin, V.P.; Tsydendambaev, V.D.; Vereshchagin, A.G.; Nosov, A.M. Lipid fatty acid composition of potato plants transformed with the Δ12-desaturase gene from cyanobacterium. Russ. J. Plant Physiol. 2007, 54, 600–606. [Google Scholar] [CrossRef]
- Calvo, A.M.; Hinze, L.L.; Gardner, H.W.; Keller, N.P. Sporogenic effect of polyunsaturated fatty acids on development of Aspergillus spp. Appl. Environ. Microbiol. 1999, 65, 3668–3673. [Google Scholar] [CrossRef]
- Tsitsigiannis, D.I.; Kowieski, T.M.; Zarnowski, R.; Keller, N.P. Three putative oxylipin biosynthetic genes integrate sexual and asexual development in Aspergillus nidulans. Microbiology (Reading) 2005, 151 Pt 6, 1809–1821. [Google Scholar] [CrossRef]
- Wang, C.; Zhang, S.; Hou, R.; Zhao, Z.; Zheng, Q.; Xu, Q.; Xu, J.R. Functional analysis of the kinome of the wheat scab fungus Fusarium graminearum. PLoS Pathog. 2011, 7, e1002460. [Google Scholar] [CrossRef]
- Hou, Z.; Xue, C.; Peng, Y.; Katan, T.; Kistler, H.C.; Xu, J.R. A mitogen-activated protein kinase gene (MGV1) in Fusarium graminearum is required for female fertility, heterokaryon formation, and plant infection. Mol. Plant Microbe Interact. 2002, 15, 1119–1127. [Google Scholar] [CrossRef]
- Zheng, Q.; Hou, R.; Zhang, J.; Ma, J.; Wu, Z.; Xu, J.R. The MAT locus genes play different roles in sexual reproduction and pathogenesis in Fusarium graminearum. PLoS ONE 2013, 8, e66980. [Google Scholar] [CrossRef]
- Catlett, N.L.; Lee, B.N.; Yoder, O.C.; Turgeon, B.G. Split-Marker Recombination for Efficient Targeted Deletion of Fungal Genes. Fungal Genet. Newsl. 2003, 50, 9–11. [Google Scholar] [CrossRef]
- Jiang, C.; Zhang, S.; Zhang, Q.; Tao, Y.; Wang, C.; Xu, J.R. FgSKN7 and FgATF1 have overlapping functions in ascosporogenesis, pathogenesis and stress responses in Fusarium graminearum. Environ. Microbiol. 2015, 17, 1245–1260. [Google Scholar] [CrossRef]
- Zheng, W.; Zhao, X.; Xie, Q.; Huang, Q.; Zhang, C.; Zhai, H.; Wang, Z. A conserved homeobox transcription factor Htf1 is required for phialide development and conidiogenesis in Fusarium species. PLoS ONE 2012, 7, e45432. [Google Scholar] [CrossRef]
- Wang, G.; Wang, C.; Hou, R.; Zhou, X.; Li, G.; Zhang, S.; Xu, J.R. The AMT1 arginine methyltransferase gene is important for plant infection and normal hyphal growth in Fusarium graminearum. PLoS ONE 2012, 7, e38324. [Google Scholar] [CrossRef]
- Bluhm, B.H.; Zhao, X.; Flaherty, J.E.; Xu, J.R.; Dunkle, L.D. RAS2 regulates growth and pathogenesis in Fusarium graminearum. Mol. Plant Microbe Interact. 2007, 20, 627–636. [Google Scholar] [CrossRef]
- Zhang, X.W.; Jia, L.J.; Zhang, Y.; Jiang, G.; Li, X.; Zhang, D.; Tang, W.H. In planta stage-specific fungal gene profiling elucidates the molecular strategies of Fusarium graminearum growing inside wheat coleoptiles. Plant Cell 2012, 24, 5159–5176. [Google Scholar] [CrossRef] [PubMed]
- Seong, K.; Hou, Z.; Tracy, M.; Kistler, H.C.; Xu, J.R. Random Insertional Mutagenesis Identifies Genes Associated with Virulence in the Wheat Scab Fungus Fusarium graminearum. Phytopathology 2005, 95, 744–750. [Google Scholar] [CrossRef] [PubMed]
- Zhao, Z.; Liu, H.; Luo, Y.; Zhou, S.; An, L.; Wang, C.; Xu, J.R. Molecular evolution and functional divergence of tubulin superfamily in the fungal tree of life. Sci. Rep. 2014, 4, 6746. [Google Scholar] [CrossRef]
- Livak, K.J.; Schmittgen, T.D. Analysis of relative gene expression data using real-time quantitative PCR and the 2(-Delta Delta C(T)) Method. Methods 2001, 25, 402–408. [Google Scholar] [CrossRef]
- King, R.; Urban, M.; Hammond-Kosack, M.C.; Hassani-Pak, K.; Hammond-Kosack, K.E. The completed genome sequence of the pathogenic ascomycete fungus Fusarium graminearum. BMC Genom. 2015, 16, 544. [Google Scholar] [CrossRef]
- Kim, D.; Langmead, B.; Salzberg, S.L. HISAT: A fast spliced aligner with low memory requirements. Nat. Methods 2015, 12, 357–360. [Google Scholar] [CrossRef]
- Pertea, M.; Pertea, G.M.; Antonescu, C.M.; Chang, T.C.; Mendell, J.T.; Salzberg, S.L. StringTie enables improved reconstruction of a transcriptome from RNA-seq reads. Nat. Biotechnol. 2015, 33, 290–295. [Google Scholar] [CrossRef]
- Cuomo, C.A.; Güldener, U.; Xu, J.R.; Trail, F.; Turgeon, B.G.; Di Pietro, A.; Kistler, H.C. The Fusarium graminearum genome reveals a link between localized polymorphism and pathogen specialization. Science 2007, 317, 1400–1402. [Google Scholar] [CrossRef]
- Chou, K.C.; Shen, H.B. A new method for predicting the subcellular localization of eukaryotic proteins with both single and multiple sites: Euk-mPLoc 2.0. PLoS ONE 2010, 5, e9931. [Google Scholar] [CrossRef]
- Velly, H.; Bouix, M.; Passot, S.; Penicaud, C.; Beinsteiner, H.; Ghorbal, S.; Fonseca, F. Cyclopropanation of unsaturated fatty acids and membrane rigidification improve the freeze-drying resistance of Lactococcus lactis subsp. lactis TOMSC161. Appl. Microbiol. Biotechnol. 2015, 99, 907–918. [Google Scholar] [CrossRef]
- Wang, J.; Zeng, W.; Cheng, J. lncRsp1, a long noncoding RNA, influences Fgsp1 expression and sexual reproduction in Fusarium graminearum. Mol. Plant Pathol. 2022, 23, 265–277. [Google Scholar] [CrossRef] [PubMed]
- Lee, J.M.; Lee, H.; Kang, S.; Park, W.J. Fatty acid desaturases, polyunsaturated fatty acid regulation, and biotechnological advances. Nutrients 2016, 8, 23. [Google Scholar] [CrossRef] [PubMed]
- Espenshade, P.J.; Hughes, A.L. Regulation of sterol synthesis in eukaryotes. Annu. Rev. Genet. 2007, 41, 401–427. [Google Scholar] [CrossRef]
- Wollam, J.; Antebi, A. Sterol regulation of metabolism, homeostasis, and development. Annu. Rev. Biochem. 2011, 80, 885–916. [Google Scholar] [CrossRef]
- Lees, N.D.; Bard, M.; Kirsch, D.R. Biochemistry and molecular biology of sterol synthesis in Saccharomyces cerevisiae. Critl. Rev. Biochem. Mol. Biol. 1999, 34, 33–47. [Google Scholar]
- Stieger, B.; Steiger, J.; Locher, K.P. Membrane lipids and transporter function. Biochim. Biophys. Acta Mol. Basis Dis. 2021, 1867, 166079. [Google Scholar] [CrossRef]
- Massey, K.A.; Nicolaou, A. Lipidomics of polyunsaturated-fatty-acid-derived oxygenated metabolites. Biochem. Soc. Trans. 2011, 39, 1240–1246. [Google Scholar] [CrossRef]
- Tezaki, S.; Iwama, R.; Kobayashi, S.; Shiwa, Y.; Yoshikawa, H.; Ohta, A.; Fukuda, R. Δ12-fatty acid desaturase is involved in growth at low temperature in yeast Yarrowia lipolytica. Biochem. Biophys. Res. Commun. 2017, 488, 165–170. [Google Scholar] [CrossRef]
- Wilson, R.A.; Calvo, A.M.; Chang, P.K.; Keller, N.P. Characterization of the Aspergillus parasiticus delta12-desaturase gene: A role for lipid metabolism in the Aspergillus-seed interaction. Microbiology (Reading) 2004, 150 Pt 9, 2881–2888. [Google Scholar] [CrossRef]
- Calvo, A.M.; Gardner, H.W.; Keller, N.P. Genetic connection between fatty acid metabolism and sporulation in Aspergillus nidulans. J. Biol. Chem. 2001, 276, 25766–25774. [Google Scholar] [CrossRef]
- Peyou-Ndi, M.M.; Watts, J.L.; Browse, J. Identification and characterization of an animal delta (12) fatty acid desaturase gene by heterologous expression in Saccharomyces cerevisiae. Arch. Biochem. Biophys. 2000, 376, 399–408. [Google Scholar] [CrossRef] [PubMed]
- Derkacz, D.; Bernat, P.; Krasowska, A. K143R Amino Acid Substitution in 14-α-Demethylase (Erg11p) Changes Plasma Membrane and Cell Wall Structure of Candida albicans. Int. J. Mol. Sci. 2022, 23, 1631. [Google Scholar] [CrossRef] [PubMed]
- Zhang, M.; Liu, Z.; Yu, Q.; Mao, J.; Zhang, B.; Xing, L.; Li, M. Deletion of genes encoding fatty acid desaturases leads to alterations in stress sensitivity in Pichia pastoris. FEMS Yeast Res. 2015, 15, fov020. [Google Scholar] [CrossRef]
- Lu, H.; Zhang, X.; Li, J.; Tg, L.E.I. Effects of adversity on fatty acid composition in fungal membrane. J. Microbiol. 2005, 25, 1–3. [Google Scholar]
- Alonso, L.; Menegatti, R.; Dorta, M.L.; Alonso, A. Plasma membrane rigidity effects of 4-hydroxy-2-nonenal in Leishmania, erythrocyte and macrophage. Toxicol. In Vitro 2022, 79, 105294. [Google Scholar] [CrossRef]
- Lepesheva, G.I.; Waterman, M.R. Sterol 14alpha-demethylase cytochrome P450 (CYP51), a P450 in all biological kingdoms. Biochim. Biophys. Acta 2007, 1770, 467–477. [Google Scholar] [CrossRef]
- Parks, L.W.; Smith, S.J.; Crowley, J.H. Biochemical and physiological effects of sterol alterations in yeast—A review. Lipids 1995, 30, 227–230. [Google Scholar] [CrossRef]
- DeJarnette, C.; Meyer, C.J.; Jenner, A.R.; Butts, A.; Peters, T.; Cheramie, M.N.; Lee, R.E. Identification of inhibitors of fungal fatty acid biosynthesis. ACS Infect. Dis. 2021, 7, 3210–3223. [Google Scholar] [CrossRef]
- Nguyen, L.N.; Trofa, D.; Nosanchuk, J.D. Fatty acid synthase impacts the pathobiology of Candida parapsilosis in vitro and during mammalian infection. PLoS ONE 2009, 4, e8421. [Google Scholar] [CrossRef]
- Xu, D.; Sillaots, S.; Davison, J.; Hu, W.; Jiang, B.; Kauffman, S.; Roemer, T. Chemical genetic profiling and characterization of small-molecule compounds that affect the biosynthesis of unsaturated fatty acids in Candida albicans. J. Biol. Chem. 2009, 284, 19754–19764. [Google Scholar] [CrossRef]
- Boedi, S.; Berger, H.; Sieber, C.; Münsterkötter, M.; Maloku, I.; Warth, B.; Strauss, J. Comparison of Fusarium graminearum transcriptomes on living or dead wheat differentiates substrate-responsive and defense-responsive genes. Front. Microbiol. 2016, 7, 1113. [Google Scholar] [CrossRef]
- Brown, N.A.; Antoniw, J.; Hammond-Kosack, K.E. The predicted secretome of the plant pathogenic fungus Fusarium graminearum: A refined comparative analysis. PLoS ONE 2012, 7, e33731. [Google Scholar] [CrossRef]
- Hsieh, S.L.; Kuo, C.M. Stearoyl-CoA desaturase expression and fatty acid composition in milkfish (Chanos chanos) and grass carp (Ctenopharyngodon idella) during cold acclimation. Comp. Biochem. Physiol. B Biochem. Mol. Biol. 2005, 141, 95–101. [Google Scholar] [CrossRef]
- Wongwathanarat, P.; Michaelson, L.V.; Carter, A.T.; Lazarus, C.M.; Griffiths, G.; Stobart, A.K.; MacKenzie, D.A. Two fatty acid delta9-desaturase genes, ole1 and ole2, from Mortierella alpina complement the yeast ole1 mutation. Microbiology (Reading) 1999, 145 Pt 10, 2939–2946. [Google Scholar] [CrossRef][Green Version]
- Okuda, T.; Ando, A.; Negoro, H.; Muratsubaki, T.; Kikukawa, H.; Sakamoto, T.; Sakuradani, E.; Shimizu, S.; Ogawa, J. Eicosapentaenoic acid (EPA) production by an oleaginous fungus Mortierella alpina expressing heterologous the Delta 17-desaturase gene under ordinary temperature. Eur. J. Lipid Sci. Tech. 2015, 117, 1919–1927. [Google Scholar] [CrossRef]
- Okuda, T.; Ando, A.; Negoro, H.; Kikukawa, H.; Sakamoto, T.; Sakuradani, E.; Ogawa, J. Omega-3 eicosatetraenoic acid production by molecular breeding of the mutant strain S14 derived from Mortierella alpina 1S-4. J. Biosci. Bioeng. 2015, 120, 299–304. [Google Scholar] [CrossRef]
- Kosa, G.; Zimmermann, B.; Kohler, A.; Ekeberg, D.; Afseth, N.K.; Mounier, J.; Shapaval, V. High-throughput screening of Mucoromycota fungi for production of low- and high-value lipids. Biotechnol. Biofuels 2018, 11, 66. [Google Scholar] [CrossRef]
- He, J.; Yang, Z.; Hu, B.; Ji, X.; Wei, Y.; Lin, L.; Zhang, Q. Correlation of polyunsaturated fatty acids with the cold adaptation of Rhodotorula glutinis. Yeast 2015, 32, 683–690. [Google Scholar] [CrossRef]
- Tan, L.; Zhuo, R.; Li, S.; Ma, F.; Zhang, X. Differential expression of desaturase genes and changes in fatty acid composition of Mortierella sp. AGED in response to environmental factors. J. Sci. Food Agric. 2017, 97, 1876–1884. [Google Scholar] [CrossRef]
Disclaimer/Publisher’s Note: The statements, opinions and data contained in all publications are solely those of the individual author(s) and contributor(s) and not of MDPI and/or the editor(s). MDPI and/or the editor(s) disclaim responsibility for any injury to people or property resulting from any ideas, methods, instructions or products referred to in the content. |
© 2024 by the authors. Licensee MDPI, Basel, Switzerland. This article is an open access article distributed under the terms and conditions of the Creative Commons Attribution (CC BY) license (https://creativecommons.org/licenses/by/4.0/).